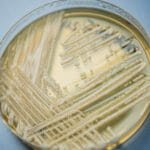

Salud Mental, una prioridad para las herramientas digitales
- Admin
- marzo 25, 2025
- Salud
- Ansiedad, Arium Salud Digital, atención psicológica, Bienestar Emocional, Depresión, Estrés, Herramientas Digitales, innovación en salud, prevención en salud mental, programas de bienestar, salud digital, Salud Laboral, Salud Mental, tecnología en salud
- 0 Comments
En 2025, la salud mental se ha consolidado como una prioridad central tanto en las políticas de salud pública como en el ámbito empresarial.
La creciente preocupación por el bienestar emocional ha impulsado un enfoque renovado hacia la atención de trastornos como el estrés, la ansiedad y la depresión, reconociendo la salud mental como un componente esencial del bienestar integral.
Con un aumento considerable en la inversión en programas de bienestar emocional, se espera que en los próximos años crezcan las herramientas digitales dirigidas a la gestión de estos trastornos.
Fedor Vidal, CEO de Arium Salud Digital, destaca que la tecnología no solo está revolucionando el acceso a la atención médica en general, sino también a las herramientas de salud mental.
Además, el enfoque hacia la salud mental se refleja en la creciente conciencia dentro de las empresas, las cuales están incorporando programas de bienestar emocional para sus empleados. La creación de espacios seguros para abordar estos temas en el entorno laboral ha demostrado ser fundamental para mejorar la productividad, reducir el ausentismo y promover un ambiente laboral más saludable.
Así, 2025 marcará un punto de inflexión en la atención a la salud mental, con un impulso decidido hacia su integración en la atención sanitaria general, y un mayor acceso a apoyo emocional a través de plataformas digitales, promoviendo una atención más accesible, personalizada y preventiva.
Arium Salud Digital
Es una empresa que provee servicios y herramientas digitales para transformar la gestión de los procesos existentes en el sector salud; mediante sistemas interconectados, y facilita la interacción entre los actores del mercado y aporta soluciones tecnológicas para su efectividad. La misión de Arium Salud Digital es proporcionar un ecosistema de salud digital que interconecte con todos los actores claves del sector, con el objetivo de mejorar la calidad de vida de la población mediante soluciones eficientes y seguras a través de tecnología de última generación.
En reyduran.com, algunas imágenes utilizadas en nuestras publicaciones provienen de fuentes externas, agencias informativas y bancos de imágenes. Todas las imágenes se emplean exclusivamente con fines periodísticos, informativos y educativos. Cada imagen incluye su respectivo crédito o referencia a la fuente original. No comercializamos, revendemos ni utilizamos las imágenes con fines promocionales o publicitarios.
Si usted es titular de derechos sobre alguna imagen publicada y considera que su uso no es adecuado, puede contactarnos a info@reyduran.com para solicitar su modificación o retiro inmediato.

Leave A Comment